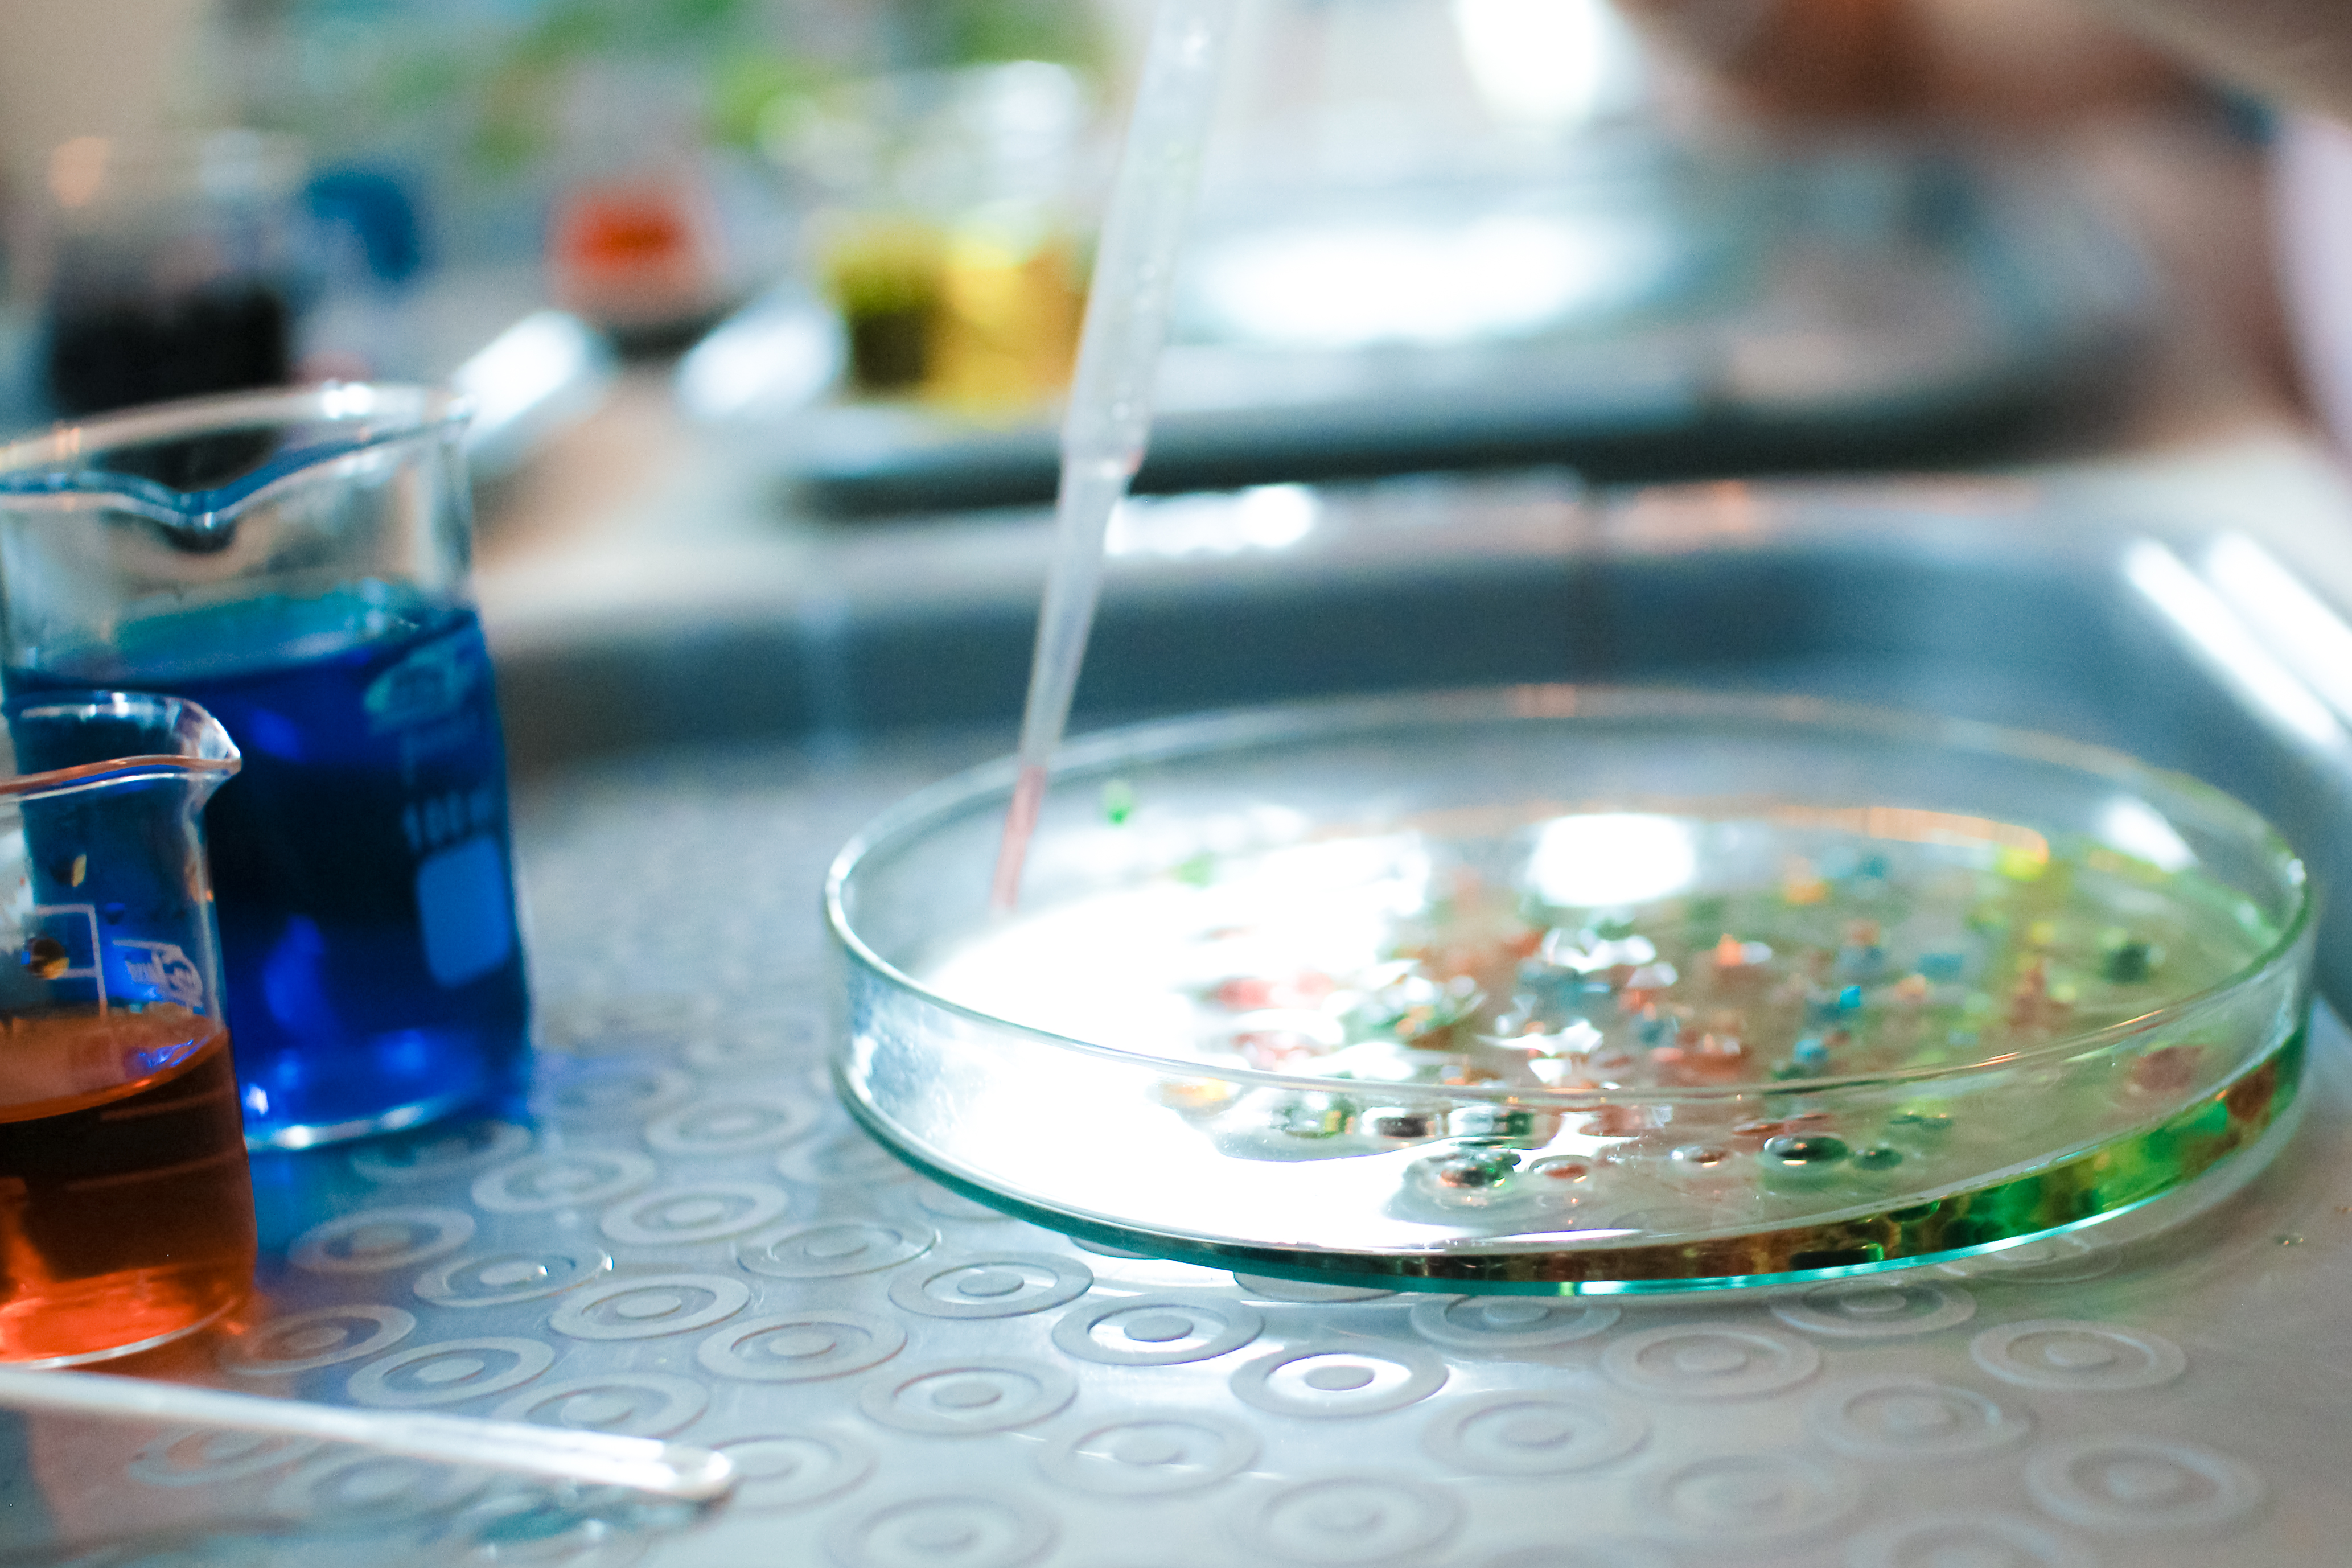

Projekt Badacze KMO -sprawdzamy czy bakterie mają pH
Dzieci z klubu Experience z klas 7-8 w Szkole Podstawowej Montessori Harmonia w Poznaniu, zafascynował ostatnio świat mikroorganizmów. Razem zaczęliśmy zastanawiać się, dlaczego jedne są nam potrzebne, a inne sprawiają nam wiele problemów. Podczas naszych spotkań omawialiśmy sposoby radzenia sobie ludzkiego organizmu z mikrobami. W trakcie tych dyskusji pojawiło się wiele pytań oraz chęci zgłębienia problemu. Tak to się zaczęło.
Stworzyliśmy projekt pod tytułem: „Czy bakterie mają pH-a?” i zgłosiliśmy go do konkursu Badacze KMO w 2018 roku. Podczas jego wykonywania chcieliśmy zbadać wpływ pH podłoża na wzrost bakterii. Poznać podstawowe techniki mikrobiologiczne. Zmierzyć się z produkcją podłoży agarowych, wreszcie spróbować opisać i przeanalizować wyniki naszych hodowli.
Zmiana pH stosowanych podłoży jest naszą zmienną, dzięki niej ocenimy, jak wpływa na wzrost drobnoustrojów. Mamy nadzieję, że wszystko nam się uda. Realizacja projektu rozpoczęliśmy częścią merytoryczną. Zgłębiliśmy wiedzę dotyczącą odczynów roztworów i ich pH (pomogła nam Pani Beata – nasza nauczycielka chemii), była to doskonała okazja do poeksperymentowania. Aktualnie tworzymy przepis na „doskonałą” pożywkę mikrobiologiczną i za chwilkę rozpoczniemy próby jej produkcji.
O naszym projekcie opowiadałam podczas Giełdy Pomysłów na VII Forum KMO. Zachęcałam również Opiekunów KMO do realizacji projektu w swoich klubach. Jeśli macie ochotę dołączyć do nas serdecznie zapraszamy. Podzielimy się naszym harmonogramem i założeniami projektu. Byłoby super gdybyśmy wspólnie mogli wymieniać doświadczenie i porównać wyniki, zapraszamy do kontaktu.
„Czy bakterie mają pH-a?” jest jednym z trzech projektów, które zwyciężyły w konkursie Badacze KMO 2018.
Konkurs Badacze KMO 2018 jest współfinansowany przez Polsko-Amerykańską Fundację Wolności